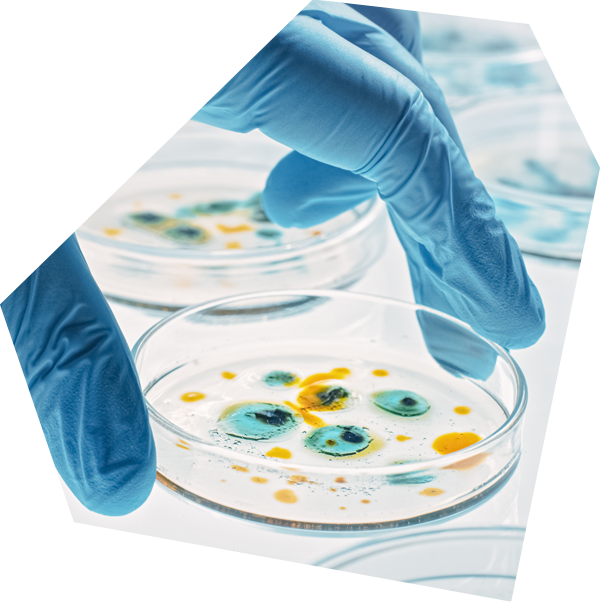
design coverage

Cyber Risk Landscape for Life Sciences
Life sciences organizations rely on digital systems to manage operations, data, and service delivery. Cyber insurance for life sciences addresses ransomware, phishing, credential theft, and system disruption. These risks impact revenue, continuity, and stakeholder confidence. Strong cyber insurance aligns with real world incidents and supports recovery.
Life sciences environments often include sensitive data, third party vendors, cloud platforms, and distributed access. This increases exposure to:
- data breaches
- social engineering
- business interruption
Cyber insurance must reflect operational realities and provide financial and operational protection.
Coverage tailored for a range of Life Science entities
Prime 100
Foundational cyber insurance for small businesses, offering essential protection against everyday cyber risks. Designed for simplicity and speed, with straightforward coverage to help organizations get started quickly.
Prime 100 Pro
Comprehensive cyber coverage for businesses with increasing digital exposure. Balances strong protection and simplicity, helping organizations manage cyber threats with confidence.
Prime 250
Flexible cyber insurance for mid-sized organizations seeking higher limits and broader protection. Combines streamlined underwriting with coverage for evolving threats across operations, data, and third-party ecosystems.
Prime One
Advanced cyber coverage designed for organizations with complex digital risk. Features modernized policy language with affirmative protection for AI-related incidents and emerging quantum computing risks.
We design coverage around...
what actually happens in a cyber event, explained in clear, simple terms that brokers can share with clients. Every policy goes beyond insurance to deliver resilience that resonates: calm, effective protection that strengthens organizations before, during, and after an incident. Policyholders have access to additional services and tools:
-
Cowbell factors™
Easy-to-understand risk ratings that reveal vulnerabilities clearly
-
Cowbell insights
Practical, actionable guidance to strengthen defenses
-
Cowbell connectors
Simple integrations with leading cloud and security providers that validate security practices—working like a constant quiet hum in the background, always active, always reinforcing protection
Activate a connector, and become eligible for a 5% premium credit*
-
Cybersecurity awareness training
Complimentary, easy-to-administer training programs that empower employees to identify threats before they turn into a cyber event**
-
Cowbell resiliency services
Practical tools and expert guidance to help businesses identify vulnerabilities, strengthen defenses, and recover faster
-
Expert claims support
24/7 in-house specialists who lead with empathy, guide recovery, and provide peace of mind when it matters most
**Cybersecurity awareness training offered through Wizer. Policyholders get unlimited seats at no additional cost for the first policy year. Email us at cybersecurity@cowbellcyber.ai to learn more.
Cowbell:

Cowbell delivers cyber insurance that cuts through complexity and adapts as risks evolve. With streamlined quoting, expert guidance, and protection designed for the realities of today’s threats, we make coverage easier to understand and more reliable when it matters most. The foundation of this approach is the Hum—our constant, steady vigilance that leads to stronger businesses, trusted partnerships, and the quiet confidence to keep moving forward.

